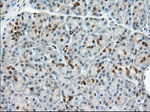
BDH2 Antibody in Immunohistochemistry (Paraffin) (IHC (P))

Search
OriGene
BDH2 Monoclonal Antibody (OTI3G10), TrueMAB™
{{$productOrderCtrl.translations['antibody.pdp.commerceCard.promotion.promotions']}}
{{$productOrderCtrl.translations['antibody.pdp.commerceCard.promotion.viewpromo']}}
{{$productOrderCtrl.translations['antibody.pdp.commerceCard.promotion.promocode']}}: {{promo.promoCode}} {{promo.promoTitle}} {{promo.promoDescription}}. {{$productOrderCtrl.translations['antibody.pdp.commerceCard.promotion.learnmore']}}
产品信息
TA501292
种属反应
宿主/亚型
分类
类型
克隆号
抗原
偶联物
形式
浓度
规格
纯化类型
保存液
内含物
保存条件
运输条件
靶标信息
Dehydrogenase that mediates the formation of 2,5-dihydroxybenzoic acid (2,5-DHBA), a siderophore that shares structural similarities with bacterial enterobactin and associates with LCN2, thereby playing a key role in iron assimilation and homeostasis. Plays a role in susceptibility to bacterial infection by providing an assimilable source of iron that is exploited by pathogenic bacteria. Also acts as a 3-hydroxybutyrate dehydrogenase (PubMed:16380372). [UniProt]
仅用于科研。不用于诊断过程。未经明确授权不得转售。
篇参考文献 (0)
生物信息学
蛋白别名: (R)-beta-hydroxybutyrate dehydrogenase; 3-hydroxybutyrate dehydrogenase type 2; 3-hydroxybutyrate dehydrogenase, type 2; 4-oxo-L-proline reductase; Dehydrogenase/reductase SDR family member 6; DHRS6; FLJ13261; Oxidoreductase UCPA; R-beta-hydroxybutyrate dehydrogenase; Short chain dehydrogenase/reductase family 15C member 1; UCPA-OR; unnamed protein product
基因别名: BDH2; DHRS6; EFA6R; PRO20933; SDR15C1; UCPA-OR; UNQ6308; UNQ6308/PRO20933
UniProt ID: (Human) Q9BUT1
Entrez Gene ID: (Human) 56898